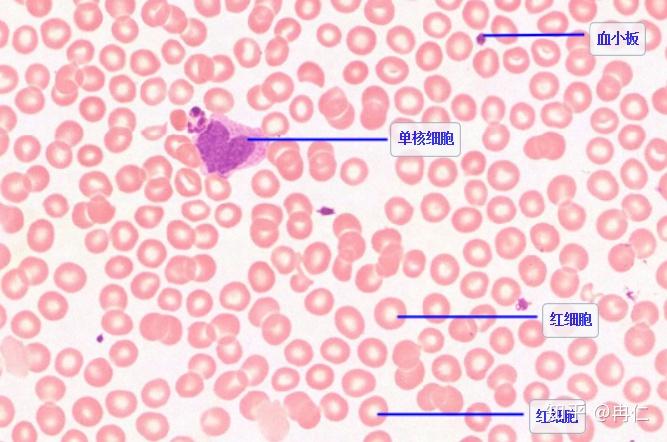
切片和涂片血细胞为什么大小不一样

血细胞图

白细胞 红细胞 人的血细胞彩图 血小板
图片尺寸1080x810
红细胞,红血细胞,解剖医学概念
图片尺寸700x394
血细胞可分为红细胞,白细胞和血小板.
图片尺寸5760x3162
医疗血液细胞.
图片尺寸1100x1100
来自医学生的~外周血细胞手绘版#医学科普 #每天学习一点点 - 抖音
图片尺寸1920x1540
如图是"用显微镜观察人血的永久涂片"实验中在显微镜下观察到的血细胞
图片尺寸587x472
血细胞
图片尺寸791x1200
血细胞
图片尺寸550x440
血液和血细胞发生课件
图片尺寸920x690
红细胞图片
图片尺寸1280x960
小鼠外周血单个核细胞的应用
图片尺寸446x350
图363血细胞
图片尺寸880x1182
红血细胞白色背景医疗科学
图片尺寸700x700
切片和涂片血细胞为什么大小不一样
图片尺寸667x442
感染新冠病毒会改变血细胞大小和硬度
图片尺寸2048x1536
各种血细胞模式图93399
图片尺寸920x1302
红血细胞显微镜在医学背景概念下
图片尺寸700x688
血细胞图谱大全ppt
图片尺寸1080x810
白血细胞在血液里3d图
图片尺寸700x467
2《细胞的多样性和统一性》ppt课件
图片尺寸1080x810